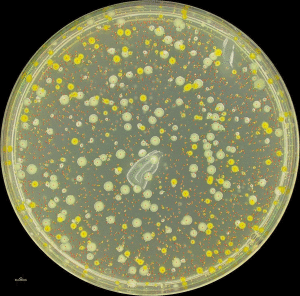
假單胞菌科 假單胞菌科

假單胞菌科
正文
細菌的1科。直或稍彎的革蘭氏陰性桿菌。大小(0.5~1)×(1.5~4)微米。以極生鞭毛運動,不形成芽孢、孢囊、鞘或突柄。化能有機營養,除單碳有機物外,能以多種有機物為碳源和能源;利用有機氮或無機氮為氮源,但不能固定分子氮;嚴格好氧,呼吸代謝,從不發酵,有的種在硝酸鹽存在時可行厭氧呼吸;生長溫度40~43℃;接觸酶陽性,氧化酶通常陽性;DNA中的G+C克分子含量為58~71%。模式屬為假單胞菌屬。假單胞菌科是 C.E.A.溫斯洛等人於 1917年建立的。1936年,A.J.勒伊沃和C.B.范尼爾提出本科包括25個屬。1974年《伯傑氏鑑定細菌學手冊》第8版中,僅包括假單胞菌屬、黃單胞菌屬、葡糖酸桿菌屬和動膠菌屬4屬。假單胞菌屬、黃單胞菌屬和弗拉特爾氏菌屬之間的親緣關係密切,應歸入本科內。葡糖酸桿菌屬雖然與弗拉特爾氏菌屬的表現性狀極為相似,但由於與醋桿菌屬的rRNA-DNA同源性高,而歸屬於醋桿菌科。1984年出版的《伯傑氏系統細菌學手冊》第1卷依此原則編排,並將表現性狀相近的動膠菌屬保留在本科內。4屬的鑑別性狀見表。
假單胞菌科